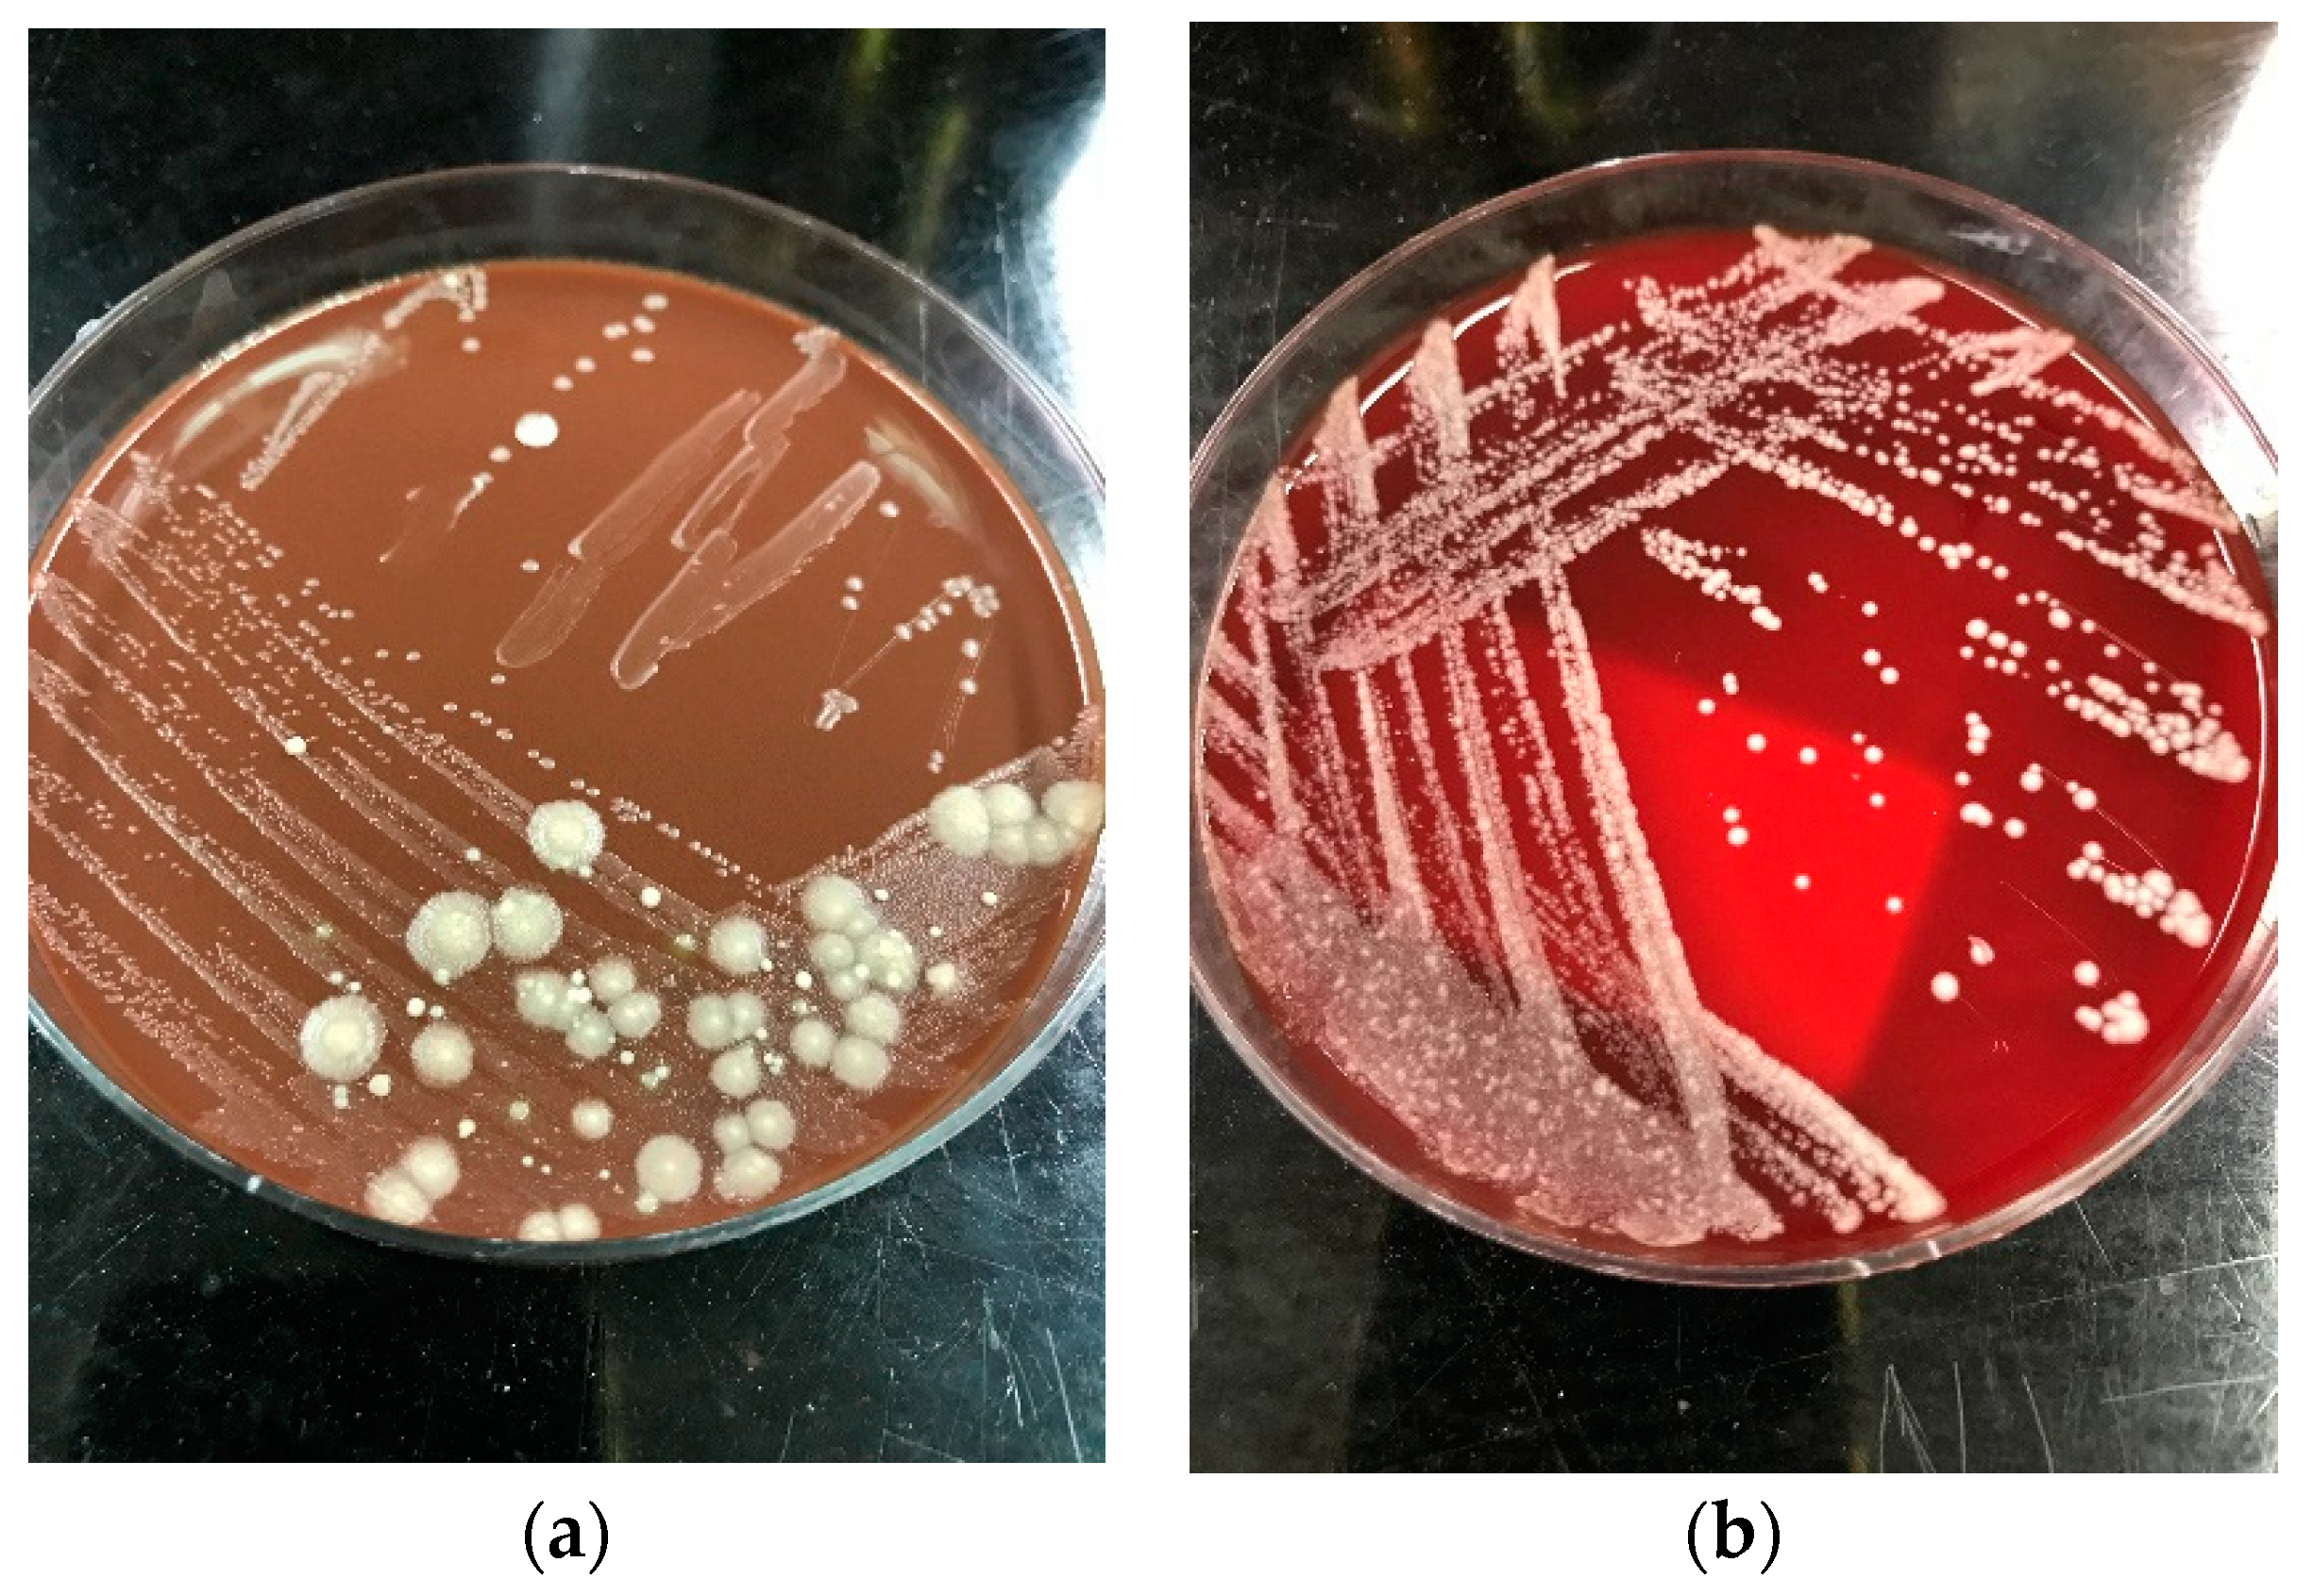
Pathogens 09 00922 g002

Invasive Saprochaete Infections: An Emerging Threat to Immunocompromised Patients
Abstract
1. Introduction
2. Epidemiology
3. Clinical Presentation
4. Diagnosis
5. Antifungal Susceptibility and Treatment
6. Conclusions
Author Contributions
Funding
Acknowledgments
Conflicts of Interest
References
- Webb, B.J.; Ferraro, J.P.; Rea, S.; Kaufusi, S.; Goodman, B.E.; Spalding, J. Epidemiology and Clinical Features of Invasive Fungal Infection in a US Health Care Network. Open Forum Infect. Dis. 2018, 5, ofy187. [Google Scholar] [CrossRef] [PubMed]
- Schmiedel, Y.; Zimmerli, S. Common invasive fungal diseases: An overview of invasive candidiasis, aspergillosis, cryptococcosis, and Pneumocystis pneumonia. Swiss. Med. Wkly 2016, 146, w14281. [Google Scholar] [CrossRef]
- Lo Cascio, G.; Vincenzi, M.; Soldani, F.; De Carolis, E.; Maccacaro, L.; Sorrentino, A.; Nadali, G.; Cesaro, S.; Sommavilla, M.; Niero, V.; et al. Outbreak of Saprochaete clavata Sepsis in Hematology Patients: Combined Use of MALDI-TOF and Sequencing Strategy to Identify and Correlate the Episodes. Front. Microbiol. 2020, 11. [Google Scholar] [CrossRef] [PubMed]
- Desnos-Ollivier, M.; Blanc, C.; Garcia-Hermoso, D.; Hoinard, D.; Alanio, A.; Dromer, F. Misidentification of Saprochaete clavata as Magnusiomyces capitatus in clinical isolates: Utility of internal transcribed spacer sequencing and matrix-assisted laser desorption ionization-time of flight mass spectrometry and importance of reliable databases. J. Clin. Microbiol. 2014, 52, 2196–2198. [Google Scholar] [CrossRef] [PubMed]
- Kaplan, E.; Al-Hatmi, A.M.S.; Ilkit, M.; Gerrits van den Ende, A.H.G.; Hagen, F.; Meis, J.F.; de Hoog, G.S. Molecular Diagnostics of Arthroconidial Yeasts, Frequent Pulmonary Opportunists. J. Clin. Microbiol. 2018, 56. [Google Scholar] [CrossRef] [PubMed]
- Hoog, G.S.; Smith, M.; Guého, E. A Revision of the Genus Geotrichum and Its Teleomorphs; Centraalbureau voar Schimmelcultures: Utrecht, The Netherlands, 1986. [Google Scholar]
- Esposto, M.C.; Prigitano, A.; Lo Cascio, G.; Ossi, C.; Grancini, A.; Cavanna, C.; Lallitto, F.; Tejada, M.; Bandettini, R.; Mularoni, A.; et al. Yeast-like filamentous fungi: Molecular identification and in vitro susceptibility study. Med. Mycol. 2019, 57, 909–913. [Google Scholar] [CrossRef] [PubMed]
- Duran Graeff, L.; Seidel, D.; Vehreschild, M.J.; Hamprecht, A.; Kindo, A.; Racil, Z.; Demeter, J.; De Hoog, S.; Aurbach, U.; Ziegler, M.; et al. Invasive infections due to Saprochaete and Geotrichum species: Report of 23 cases from the FungiScope Registry. Mycoses 2017, 60, 273–279. [Google Scholar] [CrossRef]
- Vaux, S.; Criscuolo, A.; Desnos-Ollivier, M.; Diancourt, L.; Tarnaud, C.; Vandenbogaert, M.; Brisse, S.; Coignard, B.; Dromer, F. Multicenter outbreak of infections by Saprochaete clavata, an unrecognized opportunistic fungal pathogen. mBio 2014, 5. [Google Scholar] [CrossRef]
- Yilmaz Karapinar, D.; Karadas, N.; Onder Sivis, Z.; Yazici, P.; Duyu, M.; Metin, D.; Karapinar, B.; Aydinok, Y. Rare severe mycotic infections in children receiving empirical caspofungin treatment for febrile neutropenia. Braz. J. Infect. Dis. 2015, 19, 549–552. [Google Scholar] [CrossRef]
- Buchta, V.; Bolehovská, R.; Hovorková, E.; Cornely, O.A.; Seidel, D.; Žák, P. Saprochaete clavata Invasive Infections—A New Threat to Hematological-Oncological Patients. Front. Microbiol. 2019, 10. [Google Scholar] [CrossRef]
- Parahym, A.M.; Rolim Neto, P.J.; da Silva, C.M.; Domingos Ide, F.; Goncalves, S.S.; Leite, E.P.; de Morais, V.L.; Macedo, D.P.; de Lima Neto, R.G.; Neves, R.P. Invasive infection due to Saprochaete capitata in a young patient with hematological malignancies. Braz. J. Microbiol. 2015, 46, 527–530. [Google Scholar] [CrossRef]
- Bansal, N.; Devarajan, V.; Ghafur, K.A.; Sethuraman, N.; Sree, V.L. Breakthrough Saprochaete Capitata infections among patients with hematological malignancies. Leuk Lymphoma 2018, 59, 1762–1763. [Google Scholar] [CrossRef] [PubMed]
- Pamidimukkala, U.; Kancharla, A.; Sudhaharan, S.; Gundeti, S.; Mandarapu, S.; Nagalla, V.K.; Raju, S.B.; Karanam, S.D. Isolation of the Rare Opportunistic Yeast Saprochaete capitata from Clinical Samples-Experience from a Tertiary Care Hospital in Southern India and a Brief Review of the Literature. J. Clin. Diagn. Res. 2017, 11, Dc36–Dc42. [Google Scholar] [CrossRef]
- Erman, B.; Fırtına, S.; Aksoy, B.A.; Aydogdu, S.; Genç, G.E.; Doğan, Ö.; Bozkurt, C.; Fışgın, T.; Çipe, F.E. Invasive Saprochaete capitata Infection in a Patient with Autosomal Recessive CARD9 Deficiency and a Review of the Literature. J. Clin. Immunol. 2020, 40, 466–474. [Google Scholar] [CrossRef]
- Ikuta, K.; Torimoto, Y.; Yamamoto, M.; Okamura, N.; Hosoki, T.; Sato, K.; Fujiya, M.; Kohgo, Y. Successful treatment of systemic Geotrichum capitatum infection by liposomal amphotericin-B, itraconazole, and voriconazole in a Japanese man. Intern. Med. 2010, 49, 2499–2503. [Google Scholar] [CrossRef] [PubMed][Green Version]
- Ben Neji, H.; Bchir, M.; Hamdoun, M.; Kallel, A.; Kallel, K.; Bahri, O.; Meddeb, B. Geotrichum capitatum fungemia in patients treated for acute leukemia. Med. Mal. Infect. 2019, 49, 284–286. [Google Scholar] [CrossRef] [PubMed]
- Ozdemir, Z.C.; Bozkurt Turhan, A.; Duzenli Kar, Y.; Dinleyici, C.E.; Bor, O. Fatal course of Saprochaete capitata fungemia in children with acute lymphoblastic leukemia. Pediatr. Hematol. Oncol. 2017, 34, 66–72. [Google Scholar] [CrossRef]
- Hazirolan, G.; Aypak, A.; Aksu, N. An unusual case of urinary tract infection caused by Saprochaete capitata under anidulafungin treatment. J. Mycol. Med. 2017, 27, 387–390. [Google Scholar] [CrossRef]
- Cornely, O.A.; Gachot, B.; Akan, H.; Bassetti, M.; Uzun, O.; Kibbler, C.; Marchetti, O.; de Burghgraeve, P.; Ramadan, S.; Pylkkanen, L.; et al. Epidemiology and Outcome of Fungemia in a Cancer Cohort of the Infectious Diseases Group (IDG) of the European Organization for Research and Treatment of Cancer (EORTC 65031). Clin. Infect. Dis. 2015, 61, 324–331. [Google Scholar] [CrossRef]
- Garcia-Ruiz, J.C.; Lopez-Soria, L.; Olazabal, I.; Amutio, E.; Arrieta-Aguirre, I.; Velasco-Benito, V.; Ponton, J.; Moragues, M.D. Invasive infections caused by Saprochaete capitata in patients with haematological malignancies: Report of five cases and review of the antifungal therapy. Rev. Iberoam. Micol. 2013, 30, 248–255. [Google Scholar] [CrossRef]
- Gurgui, M.; Sanchez, F.; March, F.; Lopez-Contreras, J.; Martino, R.; Cotura, A.; Galvez, M.L.; Roig, C.; Coll, P. Nosocomial outbreak of Blastoschizomyces capitatus associated with contaminated milk in a haematological unit. J. Hosp. Infect. 2011, 78, 274–278. [Google Scholar] [CrossRef]
- Döğen, A.; Kaplan, E.; Öksüz, Z.; Serin, M.S.; Ilkit, M.; de Hoog, G.S. Dishwashers are a major source of human opportunistic yeast-like fungi in indoor environments in Mersin, Turkey. Med. Mycol. 2013, 51, 493–498. [Google Scholar] [CrossRef]
- Gümral, R.; Özhak-Baysan, B.; Tümgör, A.; Saraçlı, M.A.; Yıldıran, Ş.T.; Ilkit, M.; Zupančič, J.; Novak-Babič, M.; Gunde-Cimerman, N.; Zalar, P.; et al. Dishwashers provide a selective extreme environment for human-opportunistic yeast-like fungi. Fungal. Divers. 2016, 76, 1–9. [Google Scholar] [CrossRef]
- Zalar, P.; Novak, M.; de Hoog, G.S.; Gunde-Cimerman, N. Dishwashers—A man-made ecological niche accommodating human opportunistic fungal pathogens. Fungal. Biol. 2011, 115, 997–1007. [Google Scholar] [CrossRef]
- Menu, E.; Criscuolo, A.; Desnos-Ollivier, M.; Cassagne, C.; D’Incan, E.; Furst, S.; Ranque, S.; Berger, P.; Dromer, F. Saprochaete clavata Outbreak Infecting Cancer Center through Dishwasher. Emerg. Infect. Dis. 2020, 26, 2031–2038. [Google Scholar] [CrossRef] [PubMed]
- Stanzani, M.; Cricca, M.; Sassi, C.; Sutto, E.; De Cicco, G.; Bonifazi, F.; Bertuzzi, C.; Bacci, F.; Paolini, S.; Cavo, M.; et al. Saprochaete clavata infections in patients undergoing treatment for haematological malignancies: A report of a monocentric outbreak and review of the literature. Mycoses 2019, 62, 1100–1107. [Google Scholar] [CrossRef]
- Girmenia, C.; Pagano, L.; Martino, B.; D’Antonio, D.; Fanci, R.; Specchia, G.; Melillo, L.; Buelli, M.; Pizzarelli, G.; Venditti, M.; et al. Invasive infections caused by Trichosporon species and Geotrichum capitatum in patients with hematological malignancies: A retrospective multicenter study from Italy and review of the literature. J. Clin. Microbiol. 2005, 43, 1818–1828. [Google Scholar] [CrossRef]
- Favre, S.; Rougeron, A.; Levoir, L.; Pérard, B.; Milpied, N.; Accoceberry, I.; Gabriel, F.; Vigouroux, S. Saprochaete clavata invasive infection in a patient with severe aplastic anemia: Efficacy of voriconazole and liposomal amphotericin B with adjuvant granulocyte transfusions before neutrophil recovery following allogeneic bone marrow transplantation. Med. Mycol. Case Rep. 2016, 11, 21–23. [Google Scholar] [CrossRef]
- Liu, X.; Zhou, W.; Jiang, Y.; Kuang, L. Invasive Fungal Infection Caused by Geotrichum clavatum in a Child with Acute Leukemia: First Documented Case from Mainland China. Jpn. J. Infect Dis. 2019, 72, 130–132. [Google Scholar] [CrossRef]
- Del Principe, M.I.; Sarmati, L.; Cefalo, M.; Fontana, C.; De Santis, G.; Buccisano, F.; Maurillo, L.; De Bellis, E.; Postorino, M.; Sconocchia, G.; et al. A cluster of Geotrichum clavatum (Saprochaete clavata) infection in haematological patients: A first Italian report and review of literature. Mycoses 2016, 59, 594–601. [Google Scholar] [CrossRef]
- Bretagne, S.; Renaudat, C.; Desnos-Ollivier, M.; Sitbon, K.; Lortholary, O.; Dromer, F.; Group, o.b.o.t.F.M.S. Predisposing factors and outcome of uncommon yeast species-related fungaemia based on an exhaustive surveillance programme (2002–14). J. Antimicrob. Chemother. 2017, 72, 1784–1793. [Google Scholar] [CrossRef]
- Hajar, Z.; Medawar, W.; Rizk, N. Saprochaete capitata (Geotrichum capitatum), an emerging fungal infection in kidney transplant recipients. J. Mycol. Med. 2018, 28, 387–389. [Google Scholar] [CrossRef]
- Pavone, P.; Oliva, A.; Raponi, G.; Pugliese, F.; Martelli, S.; Celli, P.; Sacco, F.; Vullo, V.; Mastroianni, C.M.; Russo, G. Disseminated fungal infection due to Saprochaete clavata in a kidney transplant recipient. J. Mycol. Med. 2019, 29, 278–281. [Google Scholar] [CrossRef]
- Mandarapu, S.; Krishna, V.; Raju, S.B.; Pamidimukkala, U.; Nimmagadda, S. Saprochaete capitata fungal infection in renal transplant recipient. Indian J. Nephrol. 2016, 26, 464–466. [Google Scholar] [CrossRef]
- Cavanna, C.; Lallitto, F.; Mangione, F.; Tamarozzi, F.; Marone, P.; Ceriana, P. Fungemia due to Saprochaete capitata in a non-neutropenic patient hospitalized in an intensive care unit after cardiac surgery. J. Mycol. Med. 2017, 27, 281–284. [Google Scholar] [CrossRef]
- Miglietta, F.; Palumbo, C.; Pizzolante, M.; Faneschi, M.L.; Cucurachi, M.; Velardi, L.; Lobreglio, G. A rare case of Saprochaete capitata fungemia in a critical ill patient without hematologic and oncological disorders. Rev. Esp. Quim. 2016, 29, 47–49. [Google Scholar]
- Chittick, P.; Palavecino, E.L.; Delashmitt, B.; Evans, J.; Peacock, J.E., Jr. Case of fatal Blastoschizomyces capitatus infection occurring in a patient receiving empiric micafungin therapy. Antimicrob. Agents Chemother. 2009, 53, 5306–5307. [Google Scholar] [CrossRef][Green Version]
- Sreeja, S.; Banashankari, G.S.; Bhavana, M.V.; Devi, D.R. Blastoschizomyces capitatus pneumonia: A rare case. Indian J. Pathol. Microbiol. 2011, 54, 846–847. [Google Scholar] [CrossRef]
- Chauhan, S.; Tiwari, S.; Singh, P.; Goyal, R. Pulmonary Infection by Blastoschizomyces capitatus in An old Tuberculosis Patient. J. Clin. Diagn. Res. Jcdr. 2015, 9, DD01–DD02. [Google Scholar] [CrossRef]
- Wills, T.S.; Degryse, A.; Lavina, J.; Sinnott, J.T. Blastoschizomyces capitatus pneumonia in an immunocompetent male. South Med. J. 2004, 97, 702–704. [Google Scholar] [CrossRef]
- Tanabe, M.B.; Patel, S.A. Blastoschizomyces capitatus pulmonary infections in immunocompetent patients: Case report, case series and literature review. Epidemiol. Infect. 2018, 146, 58–64. [Google Scholar] [CrossRef]
- Subramanya Supram, H.; Gokhale, S.; Chakrabarti, A.; Rudramurthy, S.M.; Gupta, S.; Honnavar, P. Emergence of Magnusiomyces capitatus infections in Western Nepal. Med. Mycol. 2015, 54, 103–110. [Google Scholar] [CrossRef]
- Salguero Fernandez, I.; Najera Botello, L.; Orden Martinez, B.; Roustan Gullon, G. Disseminated fungemia by Saprochaete clavata. Enferm. Infecc. Microbiol. Clin. 2019, 37, 283–284. [Google Scholar] [CrossRef] [PubMed]
- Camus, V.; Thibault, M.L.; David, M.; Gargala, G.; Compagnon, P.; Lamoureux, F.; Girault, C.; Michot, J.B.; Stamatoullas, A.; Lanic, H.; et al. Invasive Geotrichum clavatum fungal infection in an acute myeloid leukaemia patient: A case report and review. Mycopathologia 2014, 177, 319–324. [Google Scholar] [CrossRef]
- Ulu-Kilic, A.; Atalay, M.A.; Metan, G.; Cevahir, F.; Koc, N.; Eser, B.; Cetin, M.; Kaynar, L.; Alp, E. Saprochaete capitata as an emerging fungus among patients with haematological malignencies. Mycoses 2015, 58, 491–497. [Google Scholar] [CrossRef]
- Miglietta, F.; Vella, A.; Faneschi, M.L.; Lobreglio, G.; Rizzo, A.; Palumbo, C.; Palumbo, C.; Di Renzo, N.; Pizzolante, M. Geotrichum capitatum septicaemia in a haematological patient after acute myeloid leukaemia relapse: Identification using MALDI-TOF mass spectrometry and review of the literature. Infez. Med. 2015, 23, 161–167. [Google Scholar]
- Savini, V.; Catavitello, C.; Balbinot, A.; Masciarelli, G.; Astolfi, D.; Pompilio, A.; Di Bonaventura, G.; D’Amario, C.; D’Antonio, D. Multidrug-resistant Geotrichum capitatum from a haematology ward. Mycoses 2011, 54, 542–543. [Google Scholar] [CrossRef]
- Bonini, A.; Capatti, C.; Parmeggiani, M.; Gugliotta, L.; Micozzi, A.; Gentile, G.; Capria, S.; Girmenia, C. Galactomannan detection in Geotrichum capitatum invasive infections: Report of 2 new cases and review of diagnostic options. Diagn. Microbiol. Infect. Dis. 2008, 62, 450–452. [Google Scholar] [CrossRef]
- Brunetti, G.; Visconti, V.; Ghezzi, M.C.; Mantovani, S.; Ferretti, G.; Raponi, G. Management and treatment of Magnusiomyces capitatus (Geotrichum capitatum) pleural infection in a non-neutropenic patient with posaconazole. A new therapeutic opportunity? New Microbiol. 2016, 39, 307–309. [Google Scholar]
- Martino, P.; Venditti, M.; Micozzi, A.; Morace, G.; Polonelli, L.; Mantovani, M.P.; Petti, M.C.; Burgio, V.L.; Santini, C.; Serra, P.; et al. Blastoschizomyces capitatus: An emerging cause of invasive fungal disease in leukemia patients. Rev. Infect Dis. 1990, 12, 570–582. [Google Scholar] [CrossRef]
- Schuermans, C.; van Bergen, M.; Coorevits, L.; Verhaegen, J.; Lagrou, K.; Surmont, I.; Jeurissen, A. Breakthrough Saprochaete capitata infections in patients receiving echinocandins: Case report and review of the literature. Med. Mycol. 2011, 49, 414–418. [Google Scholar] [CrossRef][Green Version]
- Ersoz, G.; Otag, F.; Erturan, Z.; Aslan, G.; Kaya, A.; Emekdas, G.; Sugita, T. An outbreak of Dipodascus capitatus infection in the ICU: Three case reports and review of the literature. Jpn. J. Infect. Dis. 2004, 57, 248–252. [Google Scholar]
- Martino, R.; Salavert, M.; Parody, R.; Tomás, J.F.; de la Cámara, R.; Vázquez, L.; Jarque, I.; Prieto, E.; Sastre, J.L.; Gadea, I.; et al. Blastoschizomyces capitatus infection in patients with leukemia: Report of 26 cases. Clin. Infect. Dis. 2004, 38, 335–341. [Google Scholar] [CrossRef]
- Pérez-Sanchez, I.; Anguita, J.; Martín-Rabadan, P.; Muñoz, P.; Serrano, D.; Escudero, A.; Pintado, T. Blastoschizomyces capitatus infection in acute leukemia patients. Leuk Lymphoma 2000, 39, 209–212. [Google Scholar] [CrossRef]
- D’Antonio, D.; Parruti, G.; Pontieri, E.; Di Bonaventura, G.; Manzoli, L.; Sferra, R.; Vetuschi, A.; Piccolomini, R.; Romano, F.; Staniscia, T. Slime production by clinical isolates of Blastoschizomyces capitatus from patients with hematological malignancies and catheter-related fungemia. Eur. J. Clin. Microbiol. Infect. Dis. 2004, 23, 787–789. [Google Scholar] [CrossRef] [PubMed]
- Fraser, M.; Brown, Z.; Houldsworth, M.; Borman, A.M.; Johnson, E.M. Rapid identification of 6328 isolates of pathogenic yeasts using MALDI-ToF MS and a simplified, rapid extraction procedure that is compatible with the Bruker Biotyper platform and database. Med. Mycol. 2016, 54, 80–88. [Google Scholar] [CrossRef]
- Westblade, L.F.; Jennemann, R.; Branda, J.A.; Bythrow, M.; Ferraro, M.J.; Garner, O.B.; Ginocchio, C.C.; Lewinski, M.A.; Manji, R.; Mochon, A.B.; et al. Multicenter study evaluating the Vitek MS system for identification of medically important yeasts. J. Clin. Microbiol. 2013, 51, 2267–2272. [Google Scholar] [CrossRef]
- Lohmann, C.; Sabou, M.; Moussaoui, W.; Prévost, G.; Delarbre, J.M.; Candolfi, E.; Gravet, A.; Letscher-Bru, V. Comparison between the Biflex III-Biotyper and the Axima-SARAMIS systems for yeast identification by matrix-assisted laser desorption ionization-time of flight mass spectrometry. J. Clin. Microbiol. 2013, 51, 1231–1236. [Google Scholar] [CrossRef][Green Version]
- Viscoli, C.; Girmenia, C.; Marinus, A.; Collette, L.; Martino, P.; Vandercam, B.; Doyen, C.; Lebeau, B.; Spence, D.; Krcmery, V.; et al. Candidemia in cancer patients: A prospective, multicenter surveillance study by the Invasive Fungal Infection Group (IFIG) of the European Organization for Research and Treatment of Cancer (EORTC). Clin. Infect. Dis. 1999, 28, 1071–1079. [Google Scholar] [CrossRef]
- Picard, M.; Cassaing, S.; Letocart, P.; Verdeil, X.; Protin, C.; Chauvin, P.; Iriart, X.; Cavalie, L.; Valentin, A.; Marchou, B.; et al. Concomitant cases of disseminated Geotrichum clavatum infections in patients with acute myeloid leukemia. Leuk Lymphoma 2014, 55, 1186–1188. [Google Scholar] [CrossRef] [PubMed]
- Bodey, G.P.; Luna, M. Skin Lesions Associated With Disseminated Candidiasis. JAMA 1974, 229, 1466–1468. [Google Scholar] [CrossRef]
- Donnelly, J.P.; Chen, S.C.; Kauffman, C.A.; Steinbach, W.J.; Baddley, J.W.; Verweij, P.E.; Clancy, C.J.; Wingard, J.R.; Lockhart, S.R.; Groll, A.H.; et al. Revision and Update of the Consensus Definitions of Invasive Fungal Disease From the European Organization for Research and Treatment of Cancer and the Mycoses Study Group Education and Research Consortium. Clin. Infect. Dis. 2019. [Google Scholar] [CrossRef] [PubMed]
- Guého, E.; de Hoog, G.S.; Smith, M.T.; Meyer, S.A. DNA relatedness, taxonomy, and medical significance of Geotrichum capitatum. J. Clin. Microbiol. 1987, 25, 1191. [Google Scholar] [CrossRef]
- Kolecka, A.; Khayhan, K.; Groenewald, M.; Theelen, B.; Arabatzis, M.; Velegraki, A.; Kostrzewa, M.; Mares, M.; Taj-Aldeen, S.J.; Boekhout, T. Identification of medically relevant species of arthroconidial yeasts by use of matrix-assisted laser desorption ionization-time of flight mass spectrometry. J. Clin. Microbiol. 2013, 51, 2491–2500. [Google Scholar] [CrossRef]
- Arrieta-Aguirre, I.; Menendez-Manjon, P.; Cuetara, M.S.; Lopez-Soria, L.; Garcia-Ruiz, J.C.; Moragues, M.D. Molecular Identification of Saprochaete capitata in Human Blood and Paraffinized Tissue Samples. J. Clin. Microbiol. 2017, 55, 2556–2559. [Google Scholar] [CrossRef][Green Version]
- Bougnoux, M.E.; Brun, S.; Zahar, J.R. Healthcare-associated fungal outbreaks: New and uncommon species, New molecular tools for investigation and prevention. Antimicrob. Resist. Infect. Control. 2018, 7, 45. [Google Scholar] [CrossRef]
- Arrieta-Aguirre, I.; Menendez-Manjon, P.; Cuetara, M.S.; Fernandez de Larrinoa, I.; Garcia-Ruiz, J.C.; Moragues, M.D. Sequencing of FKS Hot Spot 1 from Saprochaete capitata To Search for a Relationship to Reduced Echinocandin Susceptibility. Antimicrob. Agents Chemother. 2018, 62. [Google Scholar] [CrossRef]
- Desnos-Ollivier, M.; Bretagne, S.; Boullie, A.; Gautier, C.; Dromer, F.; Lortholary, O. Isavuconazole MIC distribution of 29 yeast species responsible for invasive infections (2015-2017). Clin. Microbiol. Infect. 2019, 25, 634.e631–634.e634. [Google Scholar] [CrossRef]
- Etienne, A.; Datry, A.; Gaspar, N.; Morel, V.; Delabesse, E.; Lmimouni, B.; Vernant, J.P.; Dhédin, N. Successful treatment of disseminated Geotrichum capitatum infection with a combination of caspofungin and voriconazole in an immunocompromised patient. Mycoses 2008, 51, 270–272. [Google Scholar] [CrossRef]
- Fianchi, L.; Montini, L.; Caira, M.; Voso, M.T.; Maviglia, R.; Posteraro, B.; Pagano, L. Combined voriconazole plus caspofungin therapy for the treatment of probable Geotrichum pneumonia in a leukemia patient. Infection 2008, 36, 65–67. [Google Scholar] [CrossRef]
- Arendrup, M.C.; Boekhout, T.; Akova, M.; Meis, J.F.; Cornely, O.A.; Lortholary, O. ESCMID and ECMM joint clinical guidelines for the diagnosis and management of rare invasive yeast infections. Clin. Microbiol. Infect. 2014, 20 (Suppl. 3), 76–98. [Google Scholar] [CrossRef]
- Kernien, J.F.; Snarr, B.D.; Sheppard, D.C.; Nett, J.E. The Interface between Fungal Biofilms and Innate Immunity. Front. Immunol. 2018, 8, 1968. [Google Scholar] [CrossRef] [PubMed]
- Radich, R.J.; Alvarez, Z.C.; Valenzuela, R.A.; Castillo, H.F.; Moraga, V.F.; Castillo, A.J. Role of surgery in Saprochaete capitata (S. capitata) sepsis in a patient with acute myeloid leukemia. Rev. Med. Chil. 2017, 145, 1067–1071. [Google Scholar] [CrossRef]
- D’Assumpcao, C.; Lee, B.; Heidari, A. A Case of Magnusiomyces capitatus Peritonitis Without Underlying Malignancies. J. Investig. Med. High Impact Case Rep. 2018, 6, 2324709618795268. [Google Scholar] [CrossRef]
- DeMaio, J.; Colman, L. The use of adjuvant interferon-gamma therapy for hepatosplenic Blastoschizomyces capitatus infection in a patient with leukemia. Clin. Infect. Dis. 2000, 31, 822–824. [Google Scholar] [CrossRef]

| S. clavata | S. capitata | |
|---|---|---|
| Country | ||
| Outbreaks | ||
| Mortality | ||
| Risk Factors ϐ |
| |
| Source of Isolation ψ | ||
| Carbon Assimilation * |
|
|
| Growth Temperature |
| Optimal growth: 30–40 °C No growth at temperatures > 45 °C. Isolates become nonviable ω |
| MADLI-TOF Platforms Used | Successful identification
| Successful identification
|
| Presenting Symptoms | Radiographic Findings | |
|---|---|---|
| Pulmonary Involvement [17,27,29,30,35,50] |
|
|
| Intraabdominal and genitourinary Involvement [15,17,19,27,28,29,30,34,45,52] |
|
|
| Central Nervous System Involvement [10,27,44] |
|
|
| Skin Involvement [17,33,44] |
|
|
Publisher’s Note: MDPI stays neutral with regard to jurisdictional claims in published maps and institutional affiliations. |
© 2020 by the authors. Licensee MDPI, Basel, Switzerland. This article is an open access article distributed under the terms and conditions of the Creative Commons Attribution (CC BY) license (http://creativecommons.org/licenses/by/4.0/).
Share and Cite
El Zein, S.; Hindy, J.-R.; Kanj, S.S. Invasive Saprochaete Infections: An Emerging Threat to Immunocompromised Patients. Pathogens 2020, 9, 922. https://doi.org/10.3390/pathogens9110922
El Zein S, Hindy J-R, Kanj SS. Invasive Saprochaete Infections: An Emerging Threat to Immunocompromised Patients. Pathogens. 2020; 9(11):922. https://doi.org/10.3390/pathogens9110922
Chicago/Turabian StyleEl Zein, Said, Joya-Rita Hindy, and Souha S. Kanj. 2020. "Invasive Saprochaete Infections: An Emerging Threat to Immunocompromised Patients" Pathogens 9, no. 11: 922. https://doi.org/10.3390/pathogens9110922
APA StyleEl Zein, S., Hindy, J.-R., & Kanj, S. S. (2020). Invasive Saprochaete Infections: An Emerging Threat to Immunocompromised Patients. Pathogens, 9(11), 922. https://doi.org/10.3390/pathogens9110922
